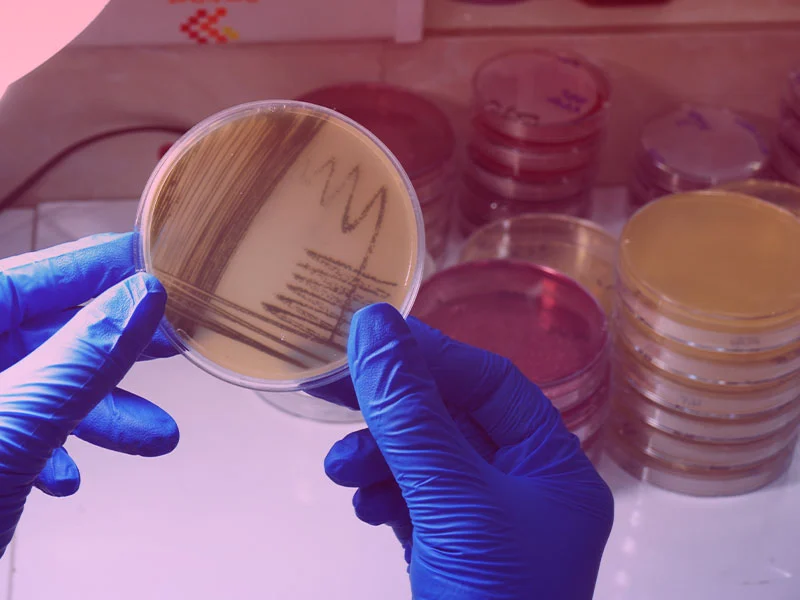
Microbi1

با اتـکاء بـر دانش و تجربیـات چندین سـاله مؤسسـین و کادر مجـرب آن در زمینـه ارائـه خدمـات آموزشـی، آزمایشگاهی و مشاوره ای در حـوزه هــای گوناگـون با هدف بسـط و گسـترش دانـش فنـی مرتبط با فعالیـت هـای تخصصی مذکـور در راسـتای مــاموریت خــود مبنی بر ارتقــاء سـطح کیفیت و تعالــی صنایـع کشـور به کمک بــرگزاری دوره هـای و کارگاه هـا تخصصــی ، ارائه خدمات آزمایشگاهی با کیفیت، ایجاد ارتباط بین صنعت و دانشگاه، ارائه راه کار و مشاوره های مطلوب جهت بهبود مدیریت در سازمان ها و صنایع کشور تشکیل گردیده است.
معرفی آزمایشگاه ها
آزمایشگاه برتر
واحد ساخت و تولید حیطه آزمایشگاهی
یکی از افتخارات آزمایشگاه معیار دانش پارس برخورداری از یک واحد مستقل ساخت، تولید و تعمیرات تجهیزات آزمایشگاهی است؛ قابلیتی که ما را از سایر آزمایشگاههای منطقه متمایز میسازد. در حالیکه بسیاری از آزمایشگاهها صرفاً مصرفکننده تجهیزات هستند و در زمان خرابی یا نیاز به ارتقاء ناچارند به تأمینکنندگان خارجی یا شرکتهای خدماتی وابسته شوند، ما با اتکا به دانش تخصصی تیم مهندسی و امکانات پیشرفته خود، توانستهایم چرخهای کامل از طراحی، ساخت، تولید، بهینهسازی و تعمیر تجهیزات آزمایشگاهی را در داخل مجموعه راهاندازی کنیم.
- دستگاه رنسیمت
- دستگاه جذب و زمان جذب آب
- تیوب های گرانیتی دستگاه جذب اتمی
- لاینر دستگاه های GC و GCMS
- تورچ دستگاه ICP
- سل های هیدرید دستگاه های جذب اتمی
- انواع فرول و بک فرول
- انواع چیلر آزمایشگاهی
آزمایشگاه برتر
آزمایشگاه کنترل کیفی سموم
سموم و آفت کش ها ترکیبات شیمیایی هستند که برای کنترل یا از بین بردن علف های هرز و حشرات مزاحم استفاده میشوند. علف کش ها علف های هرز را از بین می برند و حشره کش ها نیز حشرات مضر را از بین میبرند .به طور کلی، سم آفت کش یک ماده شیمیایی یا یک عامل بیولوژیکی مانند ویروس، باکتری، ضد میکروب یا ضد عفونی کننده است که آفات را غیرفعال کرده، کنترل کرده و از بین می رود. آفت کش ها ابزار ضروری برای محافظت از محصولات در برابر آفات و بیماری ها، تضمین عملکرد بالاتر و کاهش تلفات هستند. انتخاب آفت کش مناسب برای یک آفت یا بیماری خاص برای کنترل موثر ودر عین حال به حداقل رساندن خطرات حیاتی است.
- پایداری امولسیون
- الک تر
- قابلیت تعلیق
- اسیدیته
- قابلیت تر شوندگی
- پایداری کف
آزمایشگاه برتر
آزمایشگاه خاک و کود
در دنیای امروز، کشاورزی تنها به کشت و برداشت محصول محدود نمیشود، بلکه به یک فرآیند علمی و فناورانه تبدیل شده است که نیازمند تحلیل و مدیریت دقیق منابع است. یکی از مهمترین مؤلفههای این فرآیند، شناخت کامل وضعیت خاک و نوع کود مورد استفاده است. آزمایشگاه خاک و کود بهعنوان مرکزی تخصصی برای بررسی و ارزیابی ویژگیهای مختلف خاک و کود، نقش بسیار مهمی در بهینهسازی فعالیتهای کشاورزی ایفا میکند.
- بافت خاک
- چگالی ظاهری
- pH خاک
- تجزیه مواد آلی
- آزمون نیتروژن
- آزمون فسفر
- آزمون پتاسیم
آزمایشگاه برتر
آزمایشگاه آرایشی بهداشتی
اهمیت کیفیت محصولات آرایشی بهداشتی از زمانی که تاثیر آنها بر سلامت پوست و مو و بروز بسیاری از بیماری های پوستی پس از استفاده طولانی مدت از محصولات آرایشی بهداشتی بی کیفیت ؛ شناخته شد. با توجه به افزایش آگاهی مصرف کنندگان و تدوین استاندارد های بین الملی جدید در صنعت آرایشی بهداشتی بررسی کیفیت این محصولات مورد توجه قرار گرفت.
- فرم آلدهید
- زئین
- pH
- دانسیته
- اکسیدان
- پایداری
آزمایشگاه برتر
آزمایشگاه منسوجات
در دنیای امروز که کیفیت و استاندارد محصولات نقش کلیدی در رضایت مشتریان و موفقیت در بازارهای داخلی و بینالمللی ایفا میکند، کنترل دقیق و علمی ویژگیهای فیزیکی، شیمیایی و عملکردی منسوجات از اهمیت بالایی برخوردار است. این خدمات نه تنها به تولیدکنندگان کمک میکند تا کیفیت محصولات خود را تضمین و ارتقا دهند، بلکه مسیر را برای ورود به بازارهای جهانی هموار میسازد.
- کنترل کیفیت محصولات
- حمایت از فرآیند تحقیق و توسعه
- ارزیابی ایمنی و سلامت محصول
- افزایش اعتماد مشتریان و اعتبار برند
- پایش مستمر کیفیت در زنجیره تأمین
- مشاوره تخصصی به صنایع مرتبط
آزمایشگاه برتر
آزمایشگاه مشتقات نفتی
فرآورده های حاصل از پالایش نفت خام، در طیف گستردهای از کاربردهای صنعتی و حملونقل نقش محوری ایفا میکنند. این روغنها شامل روانکارهای موتور و صنعتی، روغنهای هیدرولیک، گریسها و سوختهای سنگین و سبک هستند که هر یک ویژگیهای فیزیکی و شیمیایی منحصر به فردی دارند.
- ایمنی و پیشگیری از حوادث
- بهینهسازی عملکرد مکانیکی
- کنترل خوردگی و حفاظت از سطوح فلزی
- Open Flash Point – ASTM D۹۲
- Close Flash Point – ASTM D۹۳
- Pour Point – ASTM D۹۷
آزمایشگاه برتر
آزمایشگاه شیمی مواد غذایی و روغن ها
امروزه اطمینان از ایمنی و سلامت مواد غذایی یکی از اصلیترین دغدغههای تولیدکنندگان، واردکنندگان و مصرفکنندگان است. روغنها، بهویژه روغنهای گیاهی، از دیرباز بهعنوان مواد ارزشمند در طب سنتی، مراقبتهای پوستی و صنایع دارویی و غذایی شناخته شدهاند. این ترکیبات غنی از اسیدهای چرب، ویتامینها، آنتیاکسیدانها و سایر مواد فعال بیولوژیکی هستند که نقش مؤثری در حفظ سلامت پوست، مو و بدن ایفا میکنند.
- کنترل کیفیت و ایمنی مواد غذایی
- رعایت استانداردهای ملی و بینالمللی
- محافظت از سلامت مصرفکننده
- تعیین کیفیت روغنهای گیاهی استخراجشده
- شناسایی ناخالصیها و آلایندههای احتمالی
- بررسی پایداری و مقاومت در برابر اکسیداسیون
آزمایشگاه برتر
آزمایشگاه بیوتکنولوژی
بخش بیوتکنولوژی بهعنوان یکی از واحدهای کلیدی در آزمایشگاه معیار دانش پارس، بستر انجام مطالعات ساختاری و عملکردی مولکولهای زیستی را فراهم میسازد. تمرکز این بخش بر بررسی فرآیندهای زیستی در سطحDNA، RNAو پروتئین است که نقشی بنیادین در درک مکانیسمهای سلولی، بیان ژن، تنظیمات اپیژنتیکی و پاسخهای زیستی به محرکهای درونی و بیرونی دارند.
- شناسایی گونه های حیوانی در گوشت چرخکرده (گاو،گوسفند، بز، شتر، اسب، الاغ، مرغ، شترمرغ، اردک، خوک، سگ، گربه و غیره)
- بررسی برچسبگذاری نادرست از نظر نوع گونه، منبع محصول و ترکیب نهایی
- بررسی اصالت تن ماهی و تعیین گونه با استفاده از PCR و سایر تکنیکهای مولکولی
- توانمندی در تشخیص وجود اجزای غیرمجاز مانند چربیهای حیوانی، بافتهای همبندی یا پروتئینهای گیاهی
آزمایشگاه برتر
آزمایشگاه میکروبیولوژی
آزمایشگاه میکروبیولوژی بهعنوان یکی از زیرساختهای حیاتی در علوم زیستی، محیطی مناسب برای مطالعه سیستماتیک ریزسازوارهها فراهم میسازد. در این فضا، با بهرهگیری از فناوریهای نوین و استانداردهای بینالمللی، امکان بررسی دقیق ویژگیهای فیزیولوژیک، ساختاری و ژنتیکی میکروارگانیسمها از جمله باکتریها، ویروسها، قارچها و پروتوزوآها مهیا میشود.
- اتاق شستشو و نظافت
- اتاق آمادهسازی محیط کشت
- اتاق آمادهسازی نمونه
- اتاق های کشت (سالم و پاتوژن)
- اتاق استریلیزاسیـون تجهیزات و محیطهای کشت
- اتاق گرمخانه گذاری و شمارش میکروارگانیسم ها
آزمایشگاه برتر
آزمایشگاه طیف سنجی مادون قرمز
طیف سنجی مادون قرمز (IR) یکی از متداولترین و پرکاربردترین روشهای طیف سنجی است که بر اساس جذب تابش و بررسی جهش های ارتعاشی مولکولها و یونهای چند اتمی کار میکند و به منظور شناسایی کیفی و کمی ترکیبات شیمیایی مختلف مورد استفاده قرار میگیرد و در تعیین ساختار ترکیبات بسیار موثر است.
- شناسایی کیفی ترکیبات
- تعیین ماهیت
- آنالیز کمی
- شناسایی ترکیبات در پزشکی قانونی
- بازیافت پلاستیک
- به دست آوردن اطلاعات مربوط به گروهای عاملی مولکولها و ساختار مولکولها
آزمایشگاه برتر
آزمایشگاه طیف سنجی جذب اتمی
طیف سنجی جذب اتمی یک تکنیک تجزیه ای برای تعیین غلظت اتمها یا یون های فلزی در یک نمونه می باشد. این روش بر اساس جذب انرژی تابشی در نواحی فرابنفش و مرئی به وسیله اتم های خنثی در حالت گازی است. در یک تجزیه جذب اتمی عنصر مورد اندازه گیری باید به حالت عنصری کاهش یابد، تبخیر شود و در مسیر عبور تابش منبع قرار گیرد، جذب تابش انجام شده متناسب با میزان جذب پرتو تابش شده توسط نمونه متناسب است.
- آب و پساب
- مواد غذایی
- فرآورده های دارویی
- خاک
- مواد معدنی
- آلیاژها
آزمایشگاه برتر
آزمایشگاه طیف سنجی نشر اتمی
طیف سنجی نشر اتمی از روشهای متداول و معمول آنالیز عناصر فلزی و غیر فلزی به شمار می رود. این روش مکمل روشهای طیف سنجی جذبی اتمی می باشد. در این روش برای برانگیخته ساختن اتمها از پلاسما به عنوان منبع انرژی استفاده میشود. دستگاه پلاسمای جفت شده القایی-طیف سنجی نشر اتمی از یک مشعل پلاسما به همراه سه لولهی متحدالمرکز از جنس کوارتز تشکیل شده است.
- مواد غذایی
- آب و پساب
- فرآورده های دارویی
- خاک
- مواد معدنی
آزمایشگاه برتر
آزمایشگاه کروماتوگرافی گازی
کروماتوگرافی گازی (Gas Chromatography) یکی از تکنیکهای پیشرفته و دقیق در علم شیمی و تجزیه و تحلیل ترکیبات است که بر پایه اصول فیزیک و شیمی استوار میباشد. این روش با جداسازی ترکیبات موجود در یک نمونه بر اساس تفاوت در زمانهای نگهداری(RT) و خصوصیات شیمیایی، امکان مطالعه دقیق ترکیبات پیچیده را فراهم میکند.
- تحلیل آلودگی محیط زیست
- صنعت نفت و گاز
- آنالیز ترکیبات آلی
- صنایع غذایی و دارویی
- ماده موثره سموم کشاورزی
آزمایشگاه برتر
آزمایشگاه کروماتوگرافی مایع
کروماتوگرافی در برگیرنده روشهای مهم و گوناگونی است که اجازه میدهد اجزای یک مخلوط پیچیده را از یکدیگر جدا کرده و هویت آنها را مشخص نماید. در حال حاضر جداسازی تجزیهایی به ویژه نمونههای چند جزئی و پیچیده، اکثراً به روش کروماتوگرافی انجام میشود و از این روش میتوان در تجزیه کمی و کیفی استفاده کرد. در بین تمام فنون جداسازی، کروماتوگرافی مایع با کارایی بالا (HPLC) یکی از پرکاربردترین روشها میباشد.
- آب و پساب
- فرآوردههای کشاورزی
- فرآوردههای دارویی
- خاک
- مواد غذایی
آکـادمی آمـوزشی معیار دانش پارس
آکادمی معیار دانش پارس به پشتوانه همکاری با اساتید مجرب و متخصص در صنعت و دانشگاه آمادگی خود را جهت اجرای بیش از 1000 عنوان دوره آموزشی مطابق با نیاز و درخواست سازمان های متقاضی اعلام می نماید.
تور مجازی شرکت معیار دانش پارس
مشاهده تور مجازی 360 درجه از تمامی آزمایشگاه ها و واحد های اداری